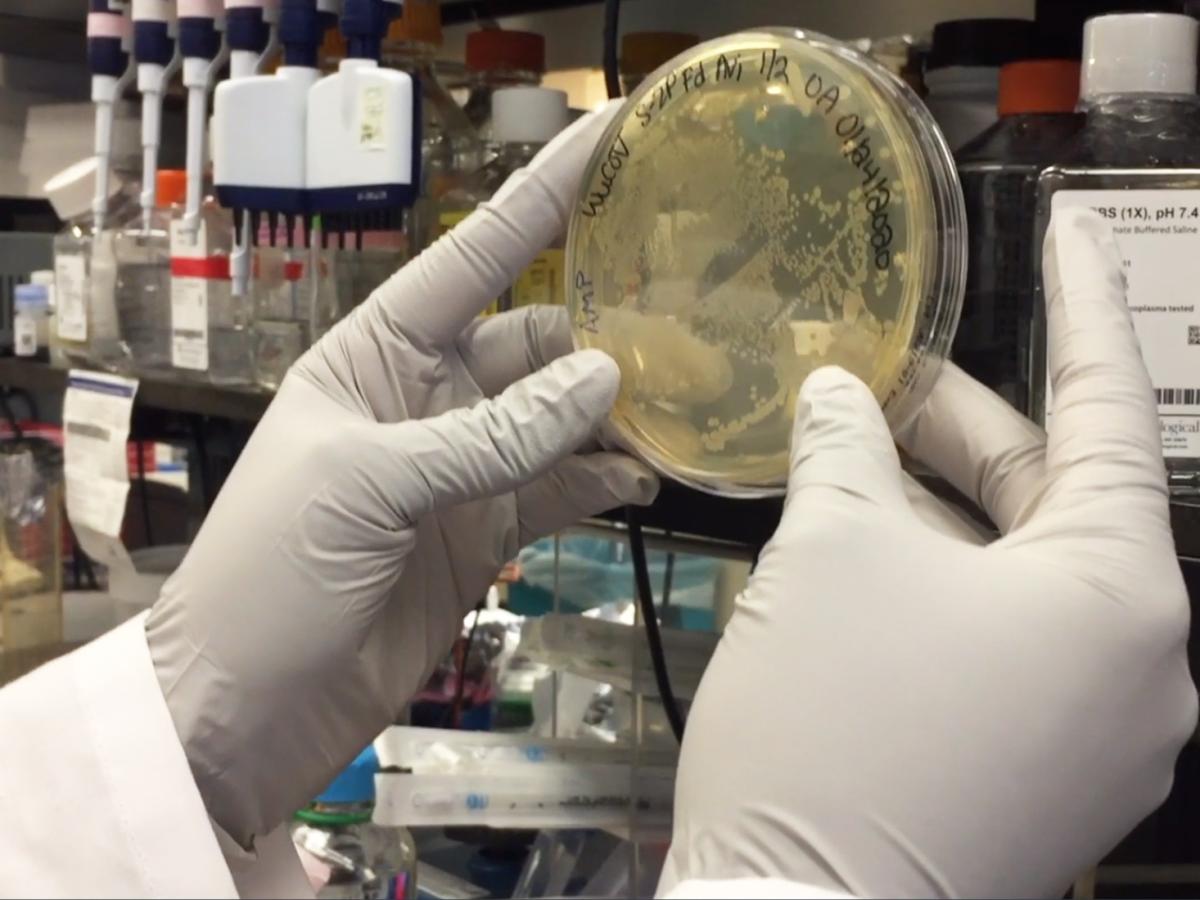

Случайная компания
Телефон: +7 499 5016828
Сайт: http://banket-restoran.ru/
E-Mail: v1977n1984@yandex.ru
Тема недели
Ленинградская область принимает участие в федеральном эксперименте по предоставлению услуг
newsinfo.ru

Юридическое название: ООО "Национальная информационная группа"
Город: Москва
Сфера бизнеса: Интернет СМИ
Просмотров: 18076
Контактная информация
Адрес: 121069, Москва, Столовый пер., д. 6, стр. 2
Телефон: 8 495 291-14-66
Сайт: http://newsinfo.ru/
E-Mail: info@newsinfo.ru
Описание
ООО "Национальная информационная группа" (сокращенно ООО "NewsInfo")
Основной вид деятельности - издание одноименного общественно-политического издания, основанного в августе 2002 года при непосредственном участии лауреата Нобелевской премии М. Горбачева. Зарегистрировано Министерством Печати как средство массовой информации "Лента "в Центре", регистрационный номер ЭЛ № 77-6583 от 22 октября 2002 года.

Открытие станции метро Кудрово запланировали на 2029 год — Дрозденко
23 декабря 2025 Станция метро "Кудрово" откроется в 2029 году — взгляд губернатора на будущее транспортной инфраструктуры и параметры её
BMW X5 стал лидером кредитных заявок на премиум авто 5–8 млн — Авито Авто
23 декабря 2025 Россияне выбирают премиум автомобили на вторичном рынке, используя кредиты. Какие модели в цене и почему удобнее брать в
Спрос на неисправные двигатели вырос на фоне дефицита запчастей — автоэксперт Ладушкин
23 декабря 2025 В России растет спрос на неисправные двигатели: дефицит новых моторов толкает рынок к восстановленным агрегатам с непредсказуемым
Опасных мутаций коронавируса не выявлено — глава Роспотребнадзора Попова
23 декабря 2025 Роспотребнадзор не фиксирует новых опасных мутаций коронавируса, но продолжает усиленный мониторинг
Меру пресечения учительнице, обвиняемой в домогательствахЮ могут смягчить — База
23 декабря 2025 Неожиданная судьба петербургской учительницы, обвиняемой в совращении школьников, повергла общественность в шок. Что стоит за возможным изменением меры
Врачи предупреждают: Дед Мороз может стать источником вшей — Мухина
23 декабря 2025 Дед Мороз может стать источником лобковых вшей для детей в случае несоответствующей гигиены. Врачи предупреждают о риске заражения через контакт и заражённые
Врачи спасли 60-летнего мужчину от потери зрения и жизни после травмы — Life.ru
23 декабря 2025 В Подмосковье врачи спасли мужчину от потери зрения и смерти после банальной травмы лба. Как промедление чуть не стоило ему
Вахрушева: маски и соблюдение гигиены — ключевые меры профилактики гриппа
23 декабря 2025 Медицинская маска и сокращение контактов — лучшие способы защиты от гонконгского гриппа, особенно в преддверии новогодних
Уникальный случай: женщина с ВИЧ болела COVID-19 два года, не заразив других
23 декабря 2025 Уникальное исследование раскрывает, как вирус SARS-CoV-2 мутировал в организме пациентки с ВИЧ и почему её болезнь не привела к заражению
Вакцинация от ВПЧ эффективна, но не лечит существующие инфекции — Чулкова
23 декабря 2025 Вакцинация остаётся самым эффективным методом профилактики ВПЧ, но не может вылечить уже существующие инфекции. Какие методы терапии доступны наВ поисках информационного агентства, которое станет настоящим другом и будет дарить вам возможность знакомиться с общей новостной картиной дня, можно провести очень много времени. Если вас не устраивает то, что публикуют федеральные издания, которые на слуху, то, возможно, ваши поиски стоящего контента могут затянуться надолго.
В сети немало изданий, которые занимаются тем, что работают с информацией. Но не все они готовы предоставлять именно то, что нужно вам.
Если ваш поиск затянулся, предлагаем ознакомиться с национальной информационной группой NewsInfo, которая в последующем, возможно, станет вашим другом и товарищем.
Любое СМИ, претендующее на ведущие роли в жизни аудитории, выбирает общественно-политическую тематику. Такой подход вполне оправдан, потому что именно в этом случае больше читателей заинтересуется контентом. NewsInfoне стало исключением.
NewsInfoпубликует новости спорта, общества, страны и мира.
Профессиональные журналисты и редакторы работают над тем, чтобы сделать картину дня полной, публикуют самые важные новости для жителей регионов России, стараются соответствовать всем пожеланиям своей огромной потенциальной аудитории.

